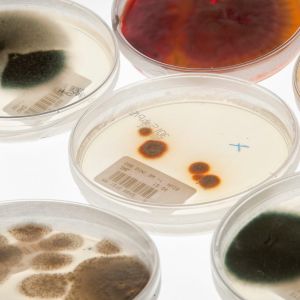

Nieuwsberichten
-
27-01-26Máxima MC en Catharina Ziekenhuis starten gezamenlijke onderneming Brainport Diagnostics en nemen laboratoria van Clinical Diagnostics PAMM B.V. over
-
18-03-25Wijziging lichtingstijden brievenbussen PostNL
-
24-06-24Tweede leven microscopen in Suriname
-
27-05-24Dag van de Zonnebrand (crème) 27 mei
-
15-05-24Uitbreiding vakgroep medische microbiologie Eurofins PAMM
-
04-12-23Elkerliek ziekenhuis verlengt samenwerking Eurofins PAMM
-
24-11-23Ook Catharina Ziekenhuis verlengt samenwerking Pathologie Eurofins PAMM
-
13-11-23Europese Antibioticadag 18-11-2023
-
26-10-23Contractverlenging pathologie Eurofins PAMM en Máxima MC
-
31-03-23Laboratoria van Gelre ziekenhuizen verbeteren dienstverlening samen met Eurofins Clinical Diagnostics
-
28-02-23
-
15-02-23Regionaal antibioticaboekje Brabant-Limburg (MMBL) vervanger van PAMM Blauw
-
06-09-22
-
06-05-22Handtekening gezet onder samenwerking Stichting PAMM en Eurofins
-
29-04-22Telefoonnummers Eurofins PAMM
-
29-04-22
-
17-02-22Stichting PAMM zet volgende stap op weg naar digitalisering
-
13-02-22Minister de Jonge inspecteert innovatieve testrobot van Nederlandse bodem
-
03-02-22Philips beloont Stichting PAMM met 100% Digitaal Award
-
27-01-22Zorgvisie interview met PAMM bestuurder Peter de Zwart
-
25-01-22Stichting PAMM zet vol in op digitale pathologie diagnostiek met Philips